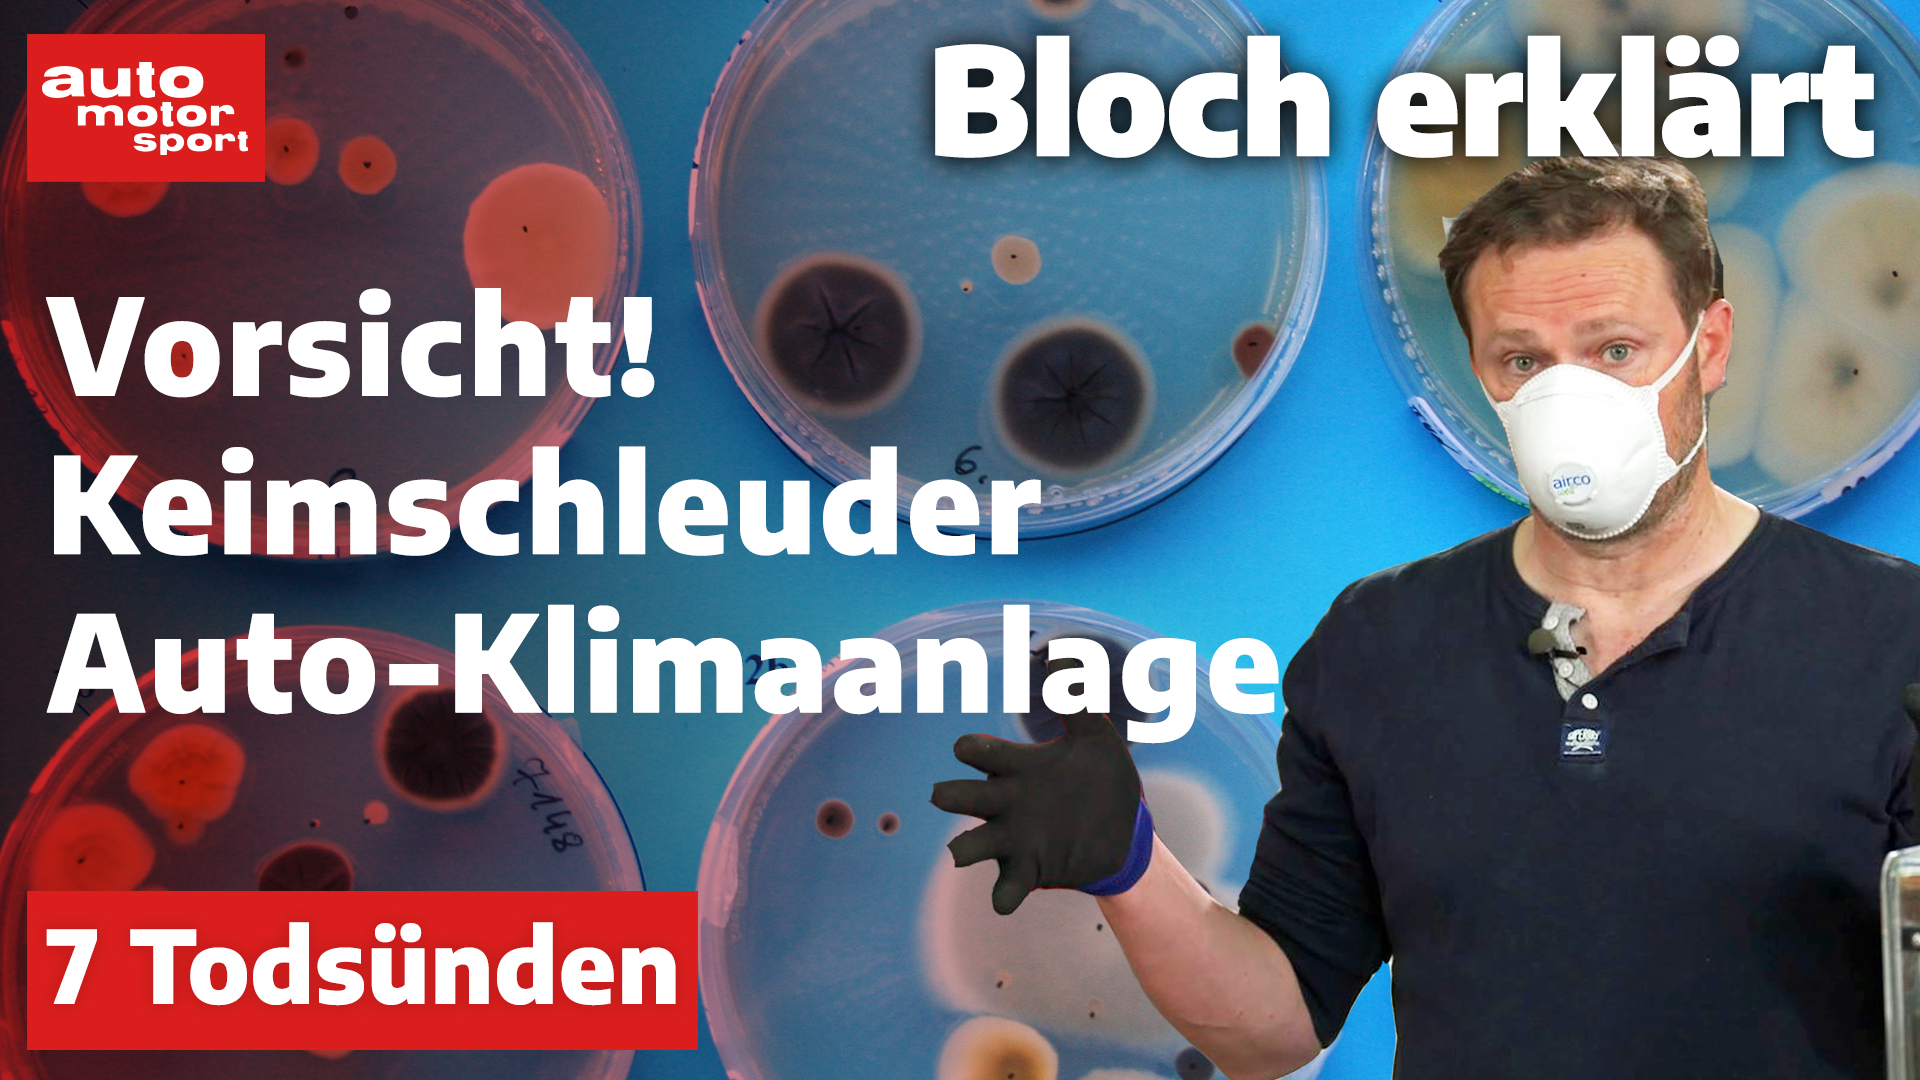
Bloch erklärt

Bloch erklärt
Unter der Motorhaube des größten Standard-Traktor der Welt brummt ein 12,4-Liter-Reihensechszylinder-Diesel. Alexander Bloch fährt den Fendt 1050 Vario auf der Teststrecke Probe. Außerdem wartet eine kleine Herausforderung auf Alex, die viel Fingerspitzengefühl erfordert.